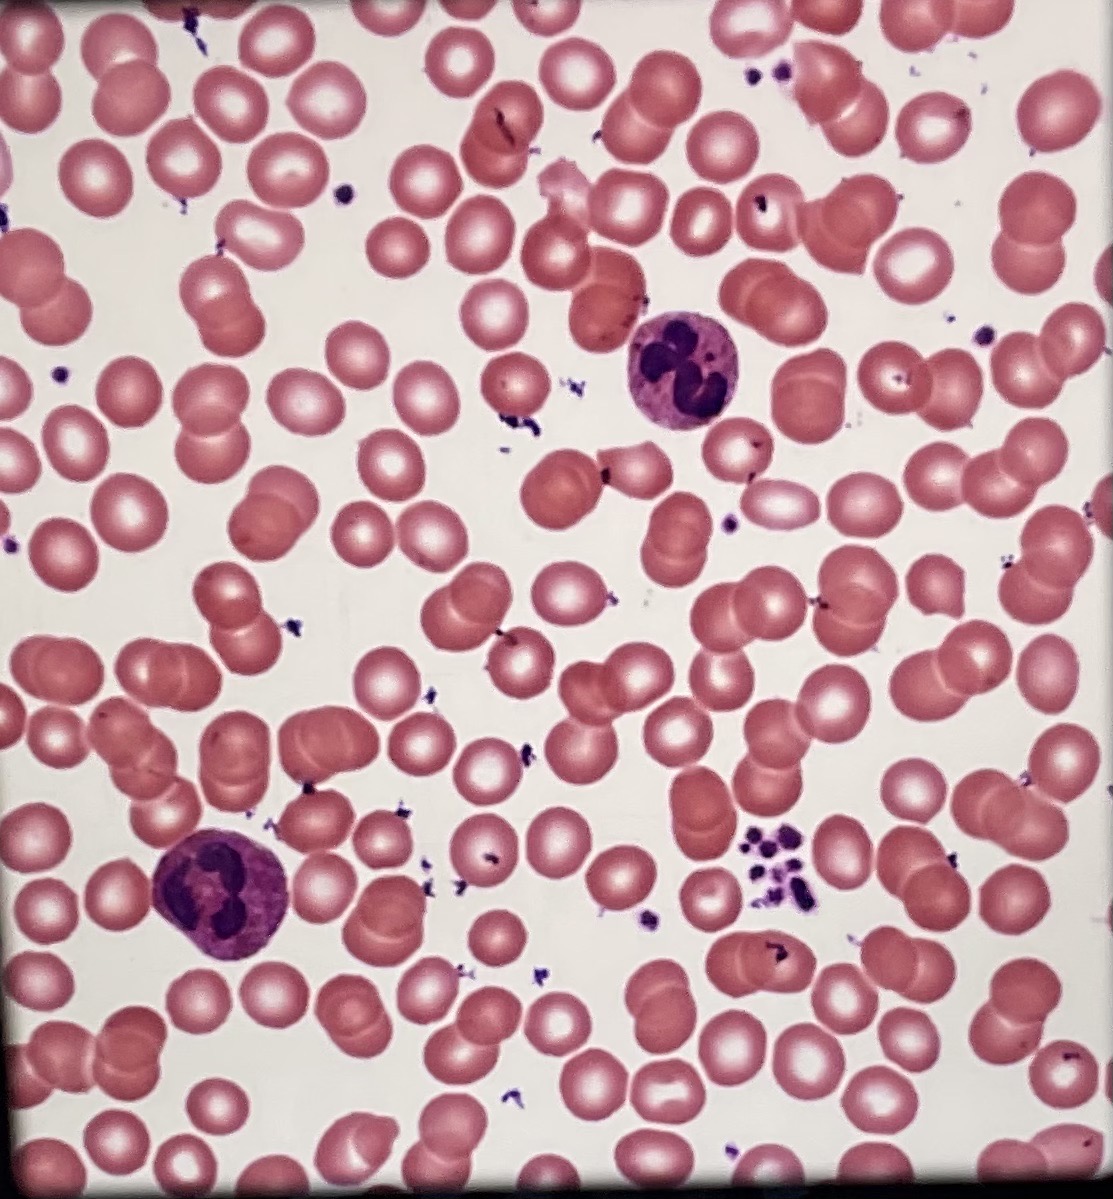
<p>What tissue type is this? What is its function?</p>
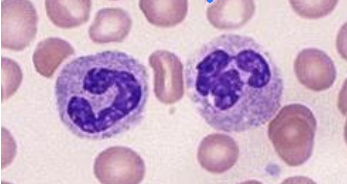
<p>Identify this leukocyte </p>
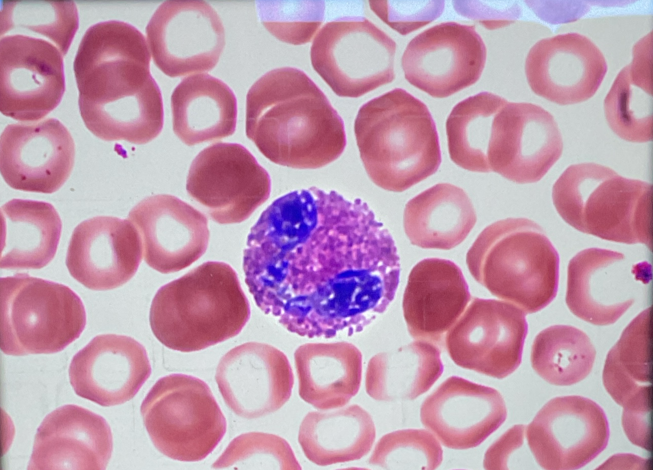
<p>Identify this leukocyte and state what color it stains</p>
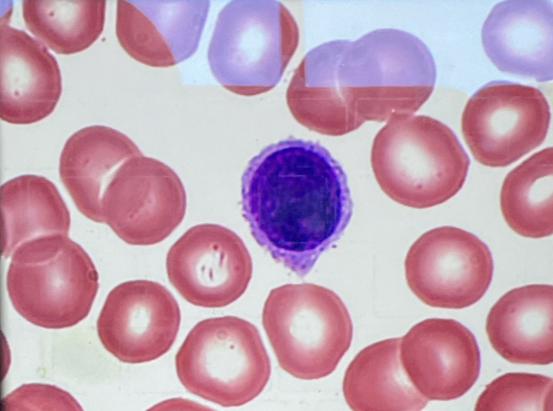
<p>Identify this leukocyte and state what color it stains</p>

KIN 272 CUMULATIVE Lab Practical
1/188
There's no tags or description
Looks like no tags are added yet.
Name | Mastery | Learn | Test | Matching | Spaced | Call with Kai |
|---|
No analytics yet
Send a link to your students to track their progress
189 Terms
This section divides the body into left and right
Sagittal
This section divides the body into anterior and posterior
Frontal/Coronal
This section divides the body into a superior and inferior half
Transverse (Horizontal)

What tissue type is this? What is its function?
Simple squamous epithelium, diffusion or filtration (found in lung alveoli)

What tissue type is this? What is its function?
Stratified squamous epithelium non-keratinized, protection from abrasion (have nuclei and are found in esophagus)

What tissue type is this? What is its function?
Simple cuboidal epithelium, absorption and secretion (found in glands)

What tissue type is this? What is its function?
Simple columnar epithelium, absorption and secretion (found in jejunum/small intestine lining)

What tissue type is this? Where is is located?
Pseudostratified columnar epithelium ciliated, trachea (lining)

What tissue type is this? What is its function?
Dense irregular connective tissue, strength

What tissue type is this? What is its function?
Hyaline cartilage, provides smooth surface and structure with flexibility (found in articular cartilage of the knee)
What tissue type is this? What is its function?
Blood (fluid connective tissue), transports O2 and nutrients

What tissue muscle type is this? What is its function?
Skeletal muscle (has multiple nuclei, striated, voluntary and found in bones)

What tissue muscle type is this? What is its function?
Cardiac muscle, (involuntary and striated, has intercalated discs)

What tissue muscle type is this? What is its function?
Smooth muscle, (spindle shaped)
Where are the antigens located?
On erythrocytes (RBCs)
Where are the antibodies located?
In plasma
What term is used to describe the clumping of RBCs due to antibodies binding to the antigens on the surface of RBCs?
Agglutination
If agglutination occurs vs if no agglutination occurs
Antigen is present on RBCs or the antigen is absent
Which blood type is the universal donor?
O-negative (no antigens on erythrocytes)
Which blood type is the universal recipient?
AB+ (no antibodies in their plasma)
Identify this leukocyte
Neutrophil (stain purple/blue and pink)
Identify this leukocyte and state what color it stains
Eosinophil (have a bilobed nucleus), distinctive reddish/orange color

Identify this leukocyte and state what color it stains
Basophil (have a bilobed nucleus), dark purple/blue color
Identify this leukocyte and state what color it stains
Lymphocyte (has a large round nucleus), dark purple/pale blue color

Identify this leukocyte and state what color it stains
Monocyte (has a large kidney-shaped nucleus), deep bluish purple color
What leukocytes are classified as granulocytes?
Neutrophils, eosinophils, and basophils
What leukocytes are classified as agranulocytes?
Lymphocytes and monocytes
What is the general difference between a granulocyte and a agranulocyte?
Presence of granules in the cytoplasm of granulocytes
Which leukocytes are the MOST abundant? What leukocytes are the LEAST abundant?
Neutrophil, basophil

Identify #1
Right atrium

Identify #2
Left atrium

Identify #3
Right ventricle

Identify #4
Left ventricle

Identify #5
Superior Vena Cava

Identify #6
Inferior Vena Cava

Identify #7
Aorta

Identify #8
Pulmonary trunk

Identify #9
Left pulmonary artery

Identify #10
Right pulmonary artery

Identify #11
Right pulmonary veins

Identify #12
Left pulmonary veins

Identify #13
Right coronary artery

Identify #14
Apex
Describe the similarities and differences observed in the tunics of a vein vs artery
In arteries, tunica media is relatively thicker and in veins, tunica externa is relatively thicker
Complete the general pathway of blood through various sizes of blood vessels
Artery, arteriole, capillary, venule, vein
Which lobes of the brain does the posterior cerebral artery and its branches run? Which lobes of the brain does the anterior cerebral artery and it’s branches run?
Occipital and temporal, frontal and parietal
Which common carotid artery branches directly from the arch of the aorta
Left common carotid (also the brachiocephalic trunk and the left subclavian artery)
Along what aspect of the arm does the brachial artery run (the radial artery and vein pass along the lateral aspect corresponding to the RADIUS)
Medial aspect of the arm
The renal artery and vein connect to what major abdominal organ
Kidney
The renal artery branches directly from what major artery
Abdominal aorta
The renal vein leads directly to which major vein of the abdomen
Inferior vena cava
Which vessel layer contains smooth muscle
Tunica media
Which vessel layer helps to anchor the vessel to the surrounding structures
Tunica externa (connective tissue)
What is vasa vasorum and where is it found
Small blood vessels in the tunica externa that provides nourishment to the other tunics
The radial artery and vein pass through what aspect of the forearm? What about the ulnar artery and vein?
Lateral, medial
Use anatomical terminology to describe the location of the adrenal (suprarenal) gland relative to the kidney
Superior to the kidney
What is the most lateral structure of the pancreas (head, body or tail). What lymphatic organ lies immediately adjacent to this part of the pancreas
Tail, the spleen
Name 2 endocrine structures are located in the cranial cavity
Hypothalamus and pituitary gland
Which lymphatic organ slowly atrophies (shrinks) during adolescence?
Thymus gland
What structure of the pancreas transmits digestive enzymes to the duodenum
Pancreatic duct
What is the most medial structure of the pancreas
Head
Describe the location of the lobes of the thyroid gland in relation to the trachea
Anterior and lateral to the trachea in the neck
Which brain structure is the primary control center for the endocrine system
Hypothalamus
Name 2 reproductive organs that have endocrine functions
Testes/ovaries
Name 2 endocrine organs located in the abdominal cavity
Pancreas and adrenal gland
What type of fluid does the spleen monitor for antigens? How is this different than lymph nodes?
Spleen monitors blood and lymph nodes monitor lymph
What tonsils are also known as “adenoids”
Pharyngeal
Which tonsils are visible by looking into the oral cavity
Palatine
What is the largest lymphatic organ and where is it located
Spleen (upper left quadrant)
What is the aggregation of lymph nodes of the ileum called?
Peyer’s patch
Where are axillary lymph nodes located
Armpit
Where are mediastinal lymph nodes located
In the mediastinal cavity (around heart)
What is the general function of lymph nodes
To filter lymph and monitor for pathogens
What are the 3 main arterial branches from the aortic arch?
Brachiocephalic trunk, left common carotid artery, left subclavian artery
When you cut a heart and get an anterior and posterior surface, what type of section is this?
Frontal
Which jugular vein drains the brain?
Internal jugular vein
What are the two types of digestion that occur in the digestive system?
Mechanical and chemical
What is the function of the epiglottis?
Prevents food and liquid from entering the trachea and lungs
What substance enters the small intestine from the liver and gall bladder?
Bile (produced in liver and stored in gallbladder)
What substances enter the small intestine from the pancreas?
Pancreatic juice (contains digestive enzymes)
What is the function of the brush border in a simple columnar epithelial cell?
Increases cell surface area and facilitates transport and absorption across the membrane
How does a villus compare to the brush border?
Villus are finger like projections of mucosa that increases surface area for absorption whereas the brush border consists of tightly packed microvilli on the lumen surface to support absorption and fluid transport
Which lung (right or left) contains 3 lobes?
Right (upper, middle, and lower lobes)
Is the cardiac notch region on the right or left lung?
Left lung
What is another name for main bronchus
Primary bronchus
What is another name for lobar bronchus
Secondary bronchus
What is another name for segmental bronchus
Tertiary bronchus
Where is alveolar (alveolus) tissue located within the respiratory tract?
The terminal bronchioles
Where is pseudo-stratified columnar epithelium (ciliated) located within the respiratory tract?
Most of the respiratory tract (Nasal cavity down to the bronchioles)
What is the role of goblet cells in the trachea?
Secrete mucus to form a protective coat along respiratory tract
What is the function of cilia in the upper respiratory tract?
Helps move mucus along the respiratory tract and act as a local defense mechanism to prevent foreign material
What type of immune cell migrates around the walls of the alveoli of the lungs?
Alveolar macrophages (defense against inhaled pathogens)
Define pulmonary ventilation:
The movement of respiratory gases between the atmosphere and alveoli of the lungs
During INSPIRATION, the vertical dimension of the thoracic cavity _____, The muscle responsible for this change is the ____
Increases, diaphragm
During INSPIRATION, the thoracic cavity ____ due to ____ of the ribs, The muscle(s) responsible for this change are the _____
Widens, elevation, external intercostals
The changes observed in the size of the thoracic cavity during INSPIRATION function to _____ the volume, which will ____ intrapulmonary pressure.
Increase, decrease
During EXPIRATION, the vertical dimension of the thoracic cavity _____, This is caused by ____ of the _____
Decreases, relaxation, diaphragm
During EXPIRATION, the thoracic cavity ______, due to ______ of the ribs, This is caused by _____ of the _____
Narrows, depression, relaxation, internal intercostals
The changes observed in the size of the thoracic cavity during EXPIRATION function to ______ the volume, which will ______ intrapulmonary pressure.
Decrease, increase
The renal artery branches from which abdominal blood vessel?
The abdominal aorta